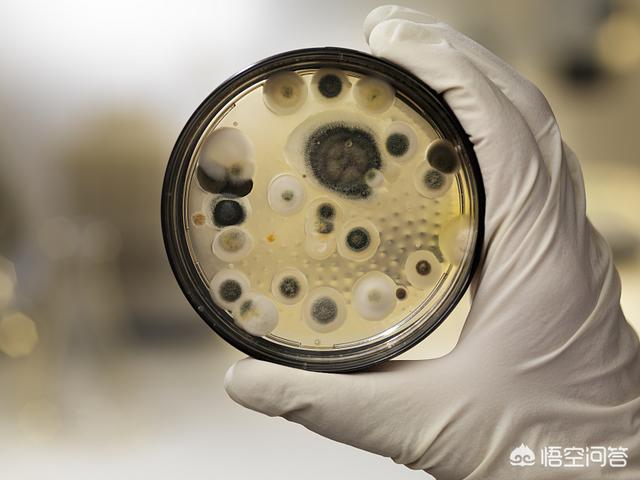

Quels sont les symptômes révélateurs d'une cirrhose ?
Quels sont les symptômes révélateurs d'une cirrhose ?
La cirrhose peut être divisée en deux stades : la cirrhose précoce est appelée cirrhose compensée et la cirrhose avancée est appelée cirrhose décompensée. La cirrhose compensée signifie que, malgré l'existence d'une cirrhose, le foie est encore à peine capable de se maintenir et que les fonctions de l'organisme peuvent encore fonctionner normalement, tandis que la cirrhose décompensée signifie que le foie s'est complètement effondré et que l'organisme est dysfonctionnel.
Le foie est un organe très résistant, et il n'est pas facile de déceler une petite lésion ou même une lésion plus importante, de sorte que de nombreuses personnes sont atteintes d'une cirrhose du foie sans le savoir. On peut donc dire que le début de la cirrhose est très insidieux, que l'on a une cirrhose sans le savoir, que la cirrhose progresse généralement plus lentement et que l'accumulation du temps conduit à l'insuffisance hépatique.
Les patients atteints de cirrhose précoce (compensée) n'ont en principe aucun symptôme, ou des symptômes très légers, seulement une petite gêne abdominale, de la fatigue, une perte d'appétit, une indigestion, etc. Ces symptômes ne sont pas permanents, ils sont intermittents, l'effort, la nervosité apparaissent et peuvent être soulagés par le repos. L'état nutritionnel au début de la cirrhose peut être celui d'une personne normale.
Par conséquent, il est très difficile d'identifier une cirrhose précoce en se basant uniquement sur les symptômes, sans parler des personnes ordinaires, même les médecins professionnels peuvent ne pas être en mesure de la voir. Afin de détecter la cirrhose à un stade précoce, nous mettons l'accent sur les examens médicaux. Si vous êtes atteint d'hépatite B, vous devriez subir une échographie abdominale ou un scanner tous les ans afin de détecter la cirrhose à un stade précoce. Si vous consommez beaucoup d'alcool, vous devez également subir une échographie abdominale tous les ans afin de détecter la cirrhose à un stade précoce.
Si la cirrhose est à un stade moyen ou avancé, les symptômes sont très évidents et c'est à ce moment-là qu'un médecin peut généralement la déceler :
1, mauvaise digestion et absorption : une cirrhose avancée entraîne une perte d'appétit importante, des nausées, une distension abdominale, etc.
2. malnutrition : léthargie, fatigue, mauvaise humeur, débilité.
3、Jaundice : la peau et la sclérotique jaunissent et la couleur de l'urine s'accentue, ce qui est dû à une atteinte des cellules du foie.
4, saignement : une cirrhose avancée affecte la fonction de coagulation, ce qui entraîne des saignements des gencives, des ecchymoses cutanées, etc.
5, vomissement de sang : lorsque les patients atteints de cirrhose ont des varices oesophagogiques, une fois les varices rompues, ils vomissent du sang.
6, ascite : la décompensation hépatique, l'hypertension portale peuvent conduire à une ascite, l'estomac du patient est bombé et plein de liquide.
Nous devons reconnaître les premiers stades de la cirrhose à un stade précoce, ce qui nous oblige à nous soumettre à des contrôles médicaux réguliers. Si vous êtes atteint d'hépatite B, suivez un traitement antiviral pour prévenir la cirrhose. Si la cirrhose est due à l'abus d'alcool, arrêtez de boire.
Aux premiers stades de la cirrhose, les symptômes ne sont pas évidents et, dans l'ensemble, il n'y a pas de grande différence avec une personne normale. Mais en y regardant de plus près, les signes sont toujours visibles. Soyez toujours attentif à ces signaux de l'organisme, qui pourraient bien vous sauver la vie en empêchant la maladie de s'aggraver.
1. régime alimentaire

Nausées et vomissements manger moins, l'une des complications de la cirrhose est qu'elle déclenche une congestion de nos intestins et de notre estomac, suivie d'un certain degré de perturbation des sécrétions gastro-intestinales (sucs digestifs) et de l'absorption (nutriments). Indigestion, reflux acide, accumulation de nourriture, vomissements s'ensuivent et la perte d'appétit est inévitable.
2. les aspects excrétoires

La diarrhée, les ballonnements et les douleurs abdominales sont les principales manifestations et sont plus fréquentes. La raison en est que, comme nous l'avons mentionné plus haut, la cirrhose provoque une congestion et une oedématiation de la paroi intestinale, ce qui entraîne un dysfonctionnement et une vulnérabilité aux infections telles que les parasites et les bactéries.
3. en termes de couleur

L'ensemble du visage est décharné et sombre, en particulier autour des yeux, car la diminution de la fonction hépatique entraîne une augmentation de la production de mélanine.
En outre, certaines personnes ressentent un état de faiblesse et se fatiguent très facilement.
(Note : Les photos proviennent du réseau, en cas d'infraction, veuillez nous contacter pour les supprimer, merci !)
La cirrhose est une sorte de maladie systémique chronique caractérisée par la dégénérescence et la nécrose des cellules hépatiques, la destruction structurelle et la fibroplasie. Cette maladie appartient à la catégorie de la médecine chinoise, telle que "gonflement", "accumulation", etc. Elle est principalement causée par l'infection au venin d'insecte, un régime alimentaire incontrôlé, l'alcoolisme excessif, une blessure interne des émotions et des sentiments, ou la transformation d'autres maladies sur une longue période, entraînant un dysfonctionnement du foie, de la rate et des reins, ce qui conduit à la stagnation du qi, à la stase du sang et à l'accumulation d'eau dans l'abdomen, et c'est un syndrome de déficience clinique, de déficience et de solidité. Cliniquement, il existe de nombreux cas de carence et de solidité, de mélange de carence et de solidité. Selon les statistiques, 80 % des patients atteints de cirrhose sont atteints d'hépatite B chronique. L'hépatite graisseuse causée par une consommation excessive d'alcool ou l'obésité est également l'une des causes de la cirrhose du foie.
Cet élément est très important pour la protection du foie. Les bourgeons de sélénium et les cinq prunes sont riches en malt de sélénium et en Schisandra, ce qui permet un double entretien du foie, une désintoxication du foie pour nourrir le foie et le sang et améliorer la capacité de désintoxication du foie. Il peut donc améliorer les maladies du foie et prévenir le cancer du foie et d'autres maladies graves.
Ces dernières années, l'incidence des maladies du foie a augmenté d'année en année, ce qui est également lié aux caractéristiques du foie lui-même, le foie est un "organe muet", parce que le foie n'a pas de nerf de la douleur, dans le stade précoce des dommages au foie, il n'y a souvent pas de manifestation de la douleur, de sorte que dans le stade précoce de la maladie du foie n'est pas perçu par les gens, par conséquent, de nombreux patients atteints de maladies du foie ont trouvé que la maladie du foie lorsque le foie a été endommagé plus sérieusement, et que le foie a été endommagé plus gravement. endommagé plus gravement. Quels sont donc les symptômes qui apparaissent dans le corps des patients atteints de cirrhose ?
I. Quels sont les symptômes de la cirrhose ?
1. perte d'appétit
Il s'agit du symptôme le plus fréquent aux premiers stades de la cirrhose, parfois accompagné de nausées et de vomissements.
2. fatigue et faiblesse
La faiblesse est due à un apport calorique insuffisant, à des lésions hépatiques ou à une mauvaise excrétion de la bile lorsque la cholinestérase sanguine est réduite, ce qui affecte les fonctions physiologiques normales des nerfs et des muscles.
3. perte de poids
Il s'agit d'un symptôme courant aux premiers stades de la cirrhose, dû à la perte d'appétit, à l'insuffisance de l'apport alimentaire et aux troubles de la digestion et de l'absorption gastro-intestinale.
4. le visage terne
En cas de cirrhose, la peau autour du visage et des yeux est plus foncée qu'auparavant, en raison des lésions hépatiques et de la réduction de la fonction hépatique, qui entraînent une augmentation de la production de mélanine.
5. douleur cachée dans la région du foie
Elle se manifeste après un effort et s'accompagne d'une jaunisse et de fièvre.
6. tendance aux hémorragies
L'hypoplasie du foie entraîne des problèmes de coagulation du sang, qui se manifestent par des saignements de gencives, des saignements de nez et des difficultés à arrêter les saignements lorsqu'ils surviennent.
II. les causes de la cirrhose
1. hépatite virale cirrhose
En Chine, la cause la plus fréquente de cirrhose est l'hépatite virale, qui comprend principalement la cirrhose de l'hépatite B, la cirrhose de l'hépatite C et la cirrhose de l'hépatite D, la cirrhose de l'hépatite B étant la plus fréquente.
2. cirrhose du foie en cas de stéatohépatite non alcoolique
Une caractéristique clinicopathologique caractérisée par un dépôt excessif de graisse et une stéatose dans les cellules du foie, due à diverses causes telles que l'obésité, le diabète sucré, l'hyperlipidémie et le syndrome métabolique.
3. cirrhose alcoolique
La cirrhose alcoolique est une lésion hépatique toxique causée par une consommation excessive d'alcool à long terme, qui se manifeste principalement par une stéatose hépatocellulaire initiale et évolue progressivement vers une hépatite alcoolique, pour finalement aboutir à une cirrhose alcoolique.
4. cirrhose toxique et pharmacologique
La cirrhose pharmacologique fait référence à une variété de poisons, de médicaments et de leurs métabolites dans le processus métabolique du foie en raison d'une variété de mécanismes qui provoquent des degrés divers de lésions hépatiques et, en fin de compte, la formation d'une cirrhose.
La cirrhose est une maladie chronique courante du foie. Pour le diagnostic clinique de la cirrhose, outre les symptômes cliniques, il est nécessaire de procéder à une série d'examens objectifs, qui serviront de base au traitement.
Suivez le Dr Hongchen, médecin spécialiste du foie, pour en savoir plus sur les maladies du foie !
La cirrhose est une lésion du foie causée par l'action prolongée ou répétée d'un ou de plusieurs facteurs étiologiques, dans la mesure où le foie est endommagé au point de présenter les caractéristiques suivantes : nécrose hépatocellulaire étendue, régénération nodulaire des hépatocytes résiduels, prolifération des tissus conjonctifs avec formation d'un septum fibreux, entraînant la destruction de la structure lobulaire du foie et la formation de pseudolobules, ainsi que la déformation et le durcissement du foie. Dans notre pays, la cirrhose est principalement causée par l'hépatite, avec une très faible proportion de cirrhose alcoolique et de cirrhose schistosomale. La cirrhose du foie présente généralement les manifestations suivantes :
1. faiblesse généralisée
Les patients atteints de cirrhose ont une fonction hépatique gravement altérée, les toxines du corps ne peuvent pas être excrétées normalement, la fonction digestive est anormale, la malnutrition, la faiblesse physique, de sorte qu'ils présentent des symptômes de faiblesse générale, parfois accompagnés d'une faible fièvre et d'une fièvre légère.
2. les manifestations anormales du système digestif
Les patients atteints de cirrhose sont sujets à des anomalies digestives telles que nausées, vomissements, perte d'appétit, ballonnements, diarrhées et ascites.
3. naevus arachnéen et hépatique sur les paumes, maladie hépatique sur le visage
Les patients atteints de cirrhose du foie présentent souvent des petits vaisseaux sanguins dilatés dans la peau du visage, du cou, de la poitrine, des épaules, des avant-bras et du dos des mains, qui ont la forme d'une araignée, d'où le nom de naevus arachnéen donné par la médecine. Les paumes des patients atteints de cirrhose sont rouges, ce que nous appelons les paumes du foie. Le visage des patients atteints de cirrhose est gris et dépourvu de sang, c'est ce qu'on appelle le visage de la maladie du foie.
3. tendance au saignement
Les patients cirrhotiques présentant une réduction des facteurs de coagulation et de la fonction prothrombique, un hypersplénisme causé par une thrombocytopénie et d'autres conditions peuvent présenter des saignements de nez répétés, des saignements des gencives, des taches de sang ou des ecchymoses sur la peau et, dans les cas graves, des hématomes.

La cirrhose est une maladie chronique qui peut être classée cliniquement en deux catégories, à savoir les stades compensés et décompensés.Les symptômes peuvent varier à différents moments et les signaux d'apparition peuvent également être influencés par l'état physique individuel du patient. Pour un meilleur diagnostic de la cirrhose, il est préférable de se rendre à l'hôpital pour effectuer des tests de la fonction hépatique et d'autres examens afin d'obtenir un jugement plus complet et plus précis de la maladie.
Lorsque le patient présente un certain inconfort physique, par exemple, au stade précoce, il se sent facilement fatigué, sa force physique est réduite, il souffre souvent d'indigestion, de ballonnements, de diarrhée, de constipation et même de douleurs au foie, il ne faut pas le prendre à la légère, il faut le traiter en temps utile, effectuer divers examens, afin de parvenir à une détection et à un traitement précoces. En particulierLes patients atteints d'hépatite B, ainsi que ceux qui souffrent d'hépatite chronique, doivent être suivis régulièrement et suivre des conseils médicaux pour éviter de développer une cirrhose.
Avec l'évolution de la maladie, certains patients atteints de cirrhose ont un visage maigre, des lèvres et une bouche sèches, et des petits vaisseaux sanguins dilatés dans les joues ; ils souffrent souvent de saignements du nez, des gencives et de la peau ; leurs yeux et leur peau jaunissent, ce que l'on appelle la jaunisse en termes médicaux.
Dans les cas graves, il peut même y avoir une accumulation de liquide dans l'abdomen, ce qui peut entraîner des complications telles qu'une hémorragie gastro-intestinale supérieure, mettant en danger la vie et la santé des patients. Si la cirrhose n'est pas contrôlée à temps, il peut y avoir un risque de cancer lorsqu'il se développe à un stade avancé, mais la plupart des patients atteints de cirrhose peuvent mieux contrôler leur état.
Des examens médicaux réguliers sont également essentiels pour prévenir la cirrhose.Pour protéger votre foie, la première chose à faire est d'éviter les soirées tardives, l'alcool et le tabac, et il est très important d'avoir une routine régulière et de veiller à se reposer suffisamment chaque jour. En outre, essayez d'adopter un régime alimentaire léger pour réduire la charge sur le foie et éviter l'apparition de la stéatose hépatique.
Cette réponse vous plaît, merci de l'aimer ou de la recommander à un(e) ami(e). Pour récolter des informations plus fiables sur le foie et la vésicule biliaire, consultez [Chirurgien hépatobiliaire Liu Bo】
La cirrhose est une maladie hépatique chronique progressive courante, qui est un trouble de la structure des tissus et entraîne un dysfonctionnement du foie, et il n'existe actuellement aucun traitement. C'est pourquoi la détection et le traitement précoces sont particulièrement importants. Quels sont donc les symptômes évidents de la cirrhose ? Parlons-en.
Tout d'abord, l'amincissement du visage, le visage sombre, plus d'1/3 des patients souffrant d'hépatite chronique ou de cirrhose, cette cirrhose dont les premiers symptômes se manifestent au niveau du visage, la peau autour des yeux est plus sombre qu'avant la maladie, c'est la fonction hépatique qui est réduite, ce qui a pour conséquence une augmentation de la production de mélanine.
Deuxièmement, les symptômes systémiques : les premiers symptômes de la cirrhose se manifestent principalement par une faiblesse, une fatigue et une perte de force physique. Un petit nombre de patients peuvent présenter une hyperpigmentation du visage.
Troisièmement, les symptômes de dyspepsie chronique : perte d'appétit, distension abdominale ou accompagnée de constipation, de diarrhée ou d'une vague douleur dans la région du foie, évidente après un effort.
Naevus en araignée : quelques symptômes précoces de la cirrhose, naevus en araignée visible, hypertrophie légère à modérée du foie, principalement observée chez les patients atteints de cirrhose alcoolique, généralement sans douleur à la pression.
Cinquièmement, la perte de poids : il s'agit de l'un des premiers symptômes de la cirrhose du foie, qui s'explique principalement par le manque d'appétit du patient, le fait qu'il ne mange pas beaucoup et les troubles digestifs, ce qui entraîne une perte de poids.
Sixièmement, les troubles hormonaux : les premiers symptômes de la cirrhose peuvent également se traduire par un gonflement des seins, un rétrécissement des testicules, le foie jouant un rôle important dans l'équilibre des hormones sexuelles dans le sang humain. Chez les femmes, les troubles des hormones sexuelles dans la cirrhose, symptômes précoces de la cirrhose, peuvent également provoquer des troubles menstruels, un rétrécissement des seins, une pilosité pubienne clairsemée, etc. Les premiers symptômes de la cirrhose étant une augmentation des œstrogènes et une diminution des androgènes, les hommes peuvent constater une hypertrophie et une distension des seins ainsi qu'une atrophie des testicules.
En résumé, lorsque vous constatez les symptômes ci-dessus, vous devez vous rendre à l'hôpital le plus rapidement possible pour confirmer le diagnostic de la maladie et suivre un traitement précoce, afin de ne pas retarder l'évolution de l'état de santé.

Cliquez sur le bas de la page [En savoir plus] pour voir plus de réponses ou poser une question au médecin gratuitement !
Suivez le numéro de téléphone du "Médecin de famille en ligne", plus de questions-réponses sur la santé faciles à consulter~~~~
Quels sont les symptômes de la cirrhose ?
Symptômes I. Manifestations cutanées
Dans les premiers stades de la cirrhose, la peau devient plus jaune que d'habitude et les muscles de la paume des mains prennent une couleur similaire à celle du foie et une forme similaire, c'est ce qu'on appelle la paume du foie, en plus d'hémorragies sous-cutanées en forme de naevus arachnéens dans de nombreuses parties de la peau. Aux stades avancés de la cirrhose, la couleur de la peau devient encore plus foncée.
Symptômes II. Système digestif
La fonction de sécrétion de la bile par les cellules du foie étant gravement affectée, la cirrhose se traduit par une mauvaise digestion, un manque d'appétit, voire des nausées et des vomissements. En raison de la stagnation de la veine cave inférieure, une grande quantité de liquide apparaît dans l'abdomen. En raison du manque d'appétit et de la mauvaise digestion, le patient peut sembler maigre.
Symptôme 3 : Tendance aux saignements
Comme la plupart des facteurs de coagulation du sang humain sont synthétisés dans le foie, si de nombreux facteurs de coagulation font défaut après une cirrhose, le corps humain est dans un état où il est très facile de saigner, et le saignement n'est pas facile à arrêter.
En outre, le foie est le lieu de synthèse des protéines et, en cas de cirrhose, la voie de synthèse des protéines est interrompue ; le patient souffrira également d'hypoprotéinémie et d'une réduction supplémentaire de l'immunité.
Le Dr Duan parle de science ☞ Vous réunir pour accroître vos connaissances !
En fait, les patients atteints de cirrhose légère ne présentent pas de symptômes évidents et typiques, et la plupart d'entre eux sont détectés lors d'une échographie, ou lorsque leur état s'aggrave et que des complications graves surviennent.

La cirrhose peut se manifester par une série de signes et de symptômes atypiques.
(1) Symptômes digestifs
Il s'agit du symptôme le plus courant chez les patients atteints de cirrhose : faiblesse, perte d'appétit, gêne dans la partie supérieure droite de l'abdomen, distension abdominale, perte de poids, diarrhée facile et, dans les cas graves, anorexie, nausées et vomissements.
(2) Couleur de la peau
Visage de la maladie du foie : la plupart des patients atteints de cirrhose ont un visage gris, sombre ou même bronzé.
Hyperpigmentation du visage, du cou et des membres supérieurs.
(3) Paumes de foie, bleus d'araignée.
Foie - rougeur sur les côtés de la surface palmaire de la main et des doigts qui se transforme en érythème floconneux.
Naevus arachnéen - de minuscules branches s'étendant vers l'extérieur avec un point rouge au centre apparaissent sur le visage, les membres supérieurs, le cou, la poitrine et le dos, ressemblant à une patte d'araignée ; le naevus arachnéen disparaît lorsque l'on appuie sur le point rouge au centre.
Les palmiers du foie et les grains de beauté se forment en raison d'une diminution de l'inactivation des œstrogènes par le foie.
(4) Anémie et hémorragie
Plus de 60 % des patients présentent une anémie légère à modérée, qui peut être associée à une splénomégalie et à un hypersplénisme.
Tendances hémorragiques, y compris pétéchies au site de prise de sang ou de perfusion, saignements de nez, saignements de gencives, règles abondantes et, dans les cas graves, saignements gastro-intestinaux et hémoptysie.
(5) Anomalies du système reproducteur
Les patients masculins présentent une atrophie des testicules, des dysfonctionnements sexuels, une perte de cheveux, une infertilité élevée et une gynécomastie.
Troubles menstruels, aménorrhée, infertilité chez la femme.
(6) La jaunisse :Jaunissement de la peau et des muqueuses, jaunissement de l'urine.
Lorsque la cirrhose s'aggrave avec des complications graves, elle peut se manifester par des symptômes typiques de décompensation de la cirrhose
(1) Ascite, œdème des membres inférieurs, liquide pleural et même épanchement péricardique. Dans les cas graves, elle peut provoquer une infection de l'ascite, qui met en jeu le pronostic vital.
(2) Hémorragie gastro-intestinale haute : vomissements de sang, selles noires, sang dans les selles.
(3) Encéphalopathie hépatique : changements précoces de la personnalité, troubles du sommeil, pertes de mémoire, lenteur de la pensée et, dans les cas graves, tremblements et même léthargie et coma.

Par conséquent, la cirrhose est négligée dans ses premiers stades en raison de l'absence de symptômes, ce qui fait des examens échographiques réguliers le moyen le plus rentable et le plus facile de détecter la cirrhose.
☞ Suivez le Dr Duan pour la santé et le bien-être !
Il y a quelques jours, mon ami d'enfance m'a envoyé un message m'informant que son père avait été diagnostiqué avec une cirrhose alcoolique du foie, une maladie très grave avec ascite et varices œsophagiennes. Il m'a envoyé une photo de son père, une photo qui m'a surpris, pas comme l'oncle sain et plein d'humour dont je me souvenais, maintenant c'est un père sombre, maigre avec seulement un abdomen soutenu par l'ascite ......
Quels sont les symptômes révélateurs d'une cirrhose ?
Symptôme 1, naevus arachnéen
Si vous remarquez que des taches rouges rayonnantes commencent à apparaître sur votre peau, avec une tache centrale rouge au milieu de la tache, il pourrait s'agir d'un grain de beauté arachnéen.

Ce type de grain de beauté est principalement dû à la dilatation des artères dans les petites ramifications de la peau, car les œstrogènes présents dans les vaisseaux sanguins doivent être inactivés par le foie, et si le foie est malade, il a tendance à dilater les capillaires et à provoquer des grains de beauté en forme d'araignée.
Par conséquent, si vous remarquez des grains de beauté sur votre visage, votre cou, votre poitrine, vos épaules ou vos bras, vous devez faire vérifier rapidement votre fonction hépatique.
Symptôme 2, palme du foie
Les personnes souffrant d'une maladie du foie sont sujettes aux "palmiers du foie". Si vous constatez la présence de grandes taches rouges sur vos paumes, ou si elles sont congestionnées et deviennent blanches lorsqu'on les presse, il se peut que vous ayez un problème de foie.

Non seulement la paume des mains, mais aussi la plante des pieds, et si cela se produit pendant une longue période, cela peut entraîner une atrophie des testicules chez les hommes, une croissance des seins ou des troubles menstruels chez les femmes.
Symptôme 3, peau foncée
Dans notre vie quotidienne, il n'est pas difficile de constater que la plupart des patients atteints d'une maladie du foie ont une peau jaune foncé, même s'ils utilisent davantage de produits blanchissants.
C'est le visage de la maladie du foie, qui se manifeste par un assombrissement progressif de la peau, un assombrissement, un noircissement, voire un "bronzage", et dans certains cas, des "yeux de panda" autour des yeux.
C'est surtout si une personne au teint clair n'a pas été exposée au soleil ces dernières années, mais que son teint s'assombrit, qu'il faut se méfier.

3 types d'aliments sont responsables de la cirrhose du foie ; si l'on en mange plus, le foie sera "mauvais".
1. la nourriture avariée
Les personnes vivant dans des régions humides constateront que des taches vertes et des moisissures peuvent facilement se développer si les aliments ne sont pas conservés au sec et hermétiquement.
En particulier, les aliments de base tels que les brioches et le pain cuits à la vapeur sont susceptibles de coller, d'avoir des taches vertes et une coloration verte lorsqu'ils sont laissés pendant une longue période, ce qui peut entraîner le développement de l'aflatoxine, une mycotoxine hautement toxique.
La nocivité de l'aflatoxine se manifeste principalement par sa toxicité pour le foie, qui provoque une intoxication alimentaire après consommation et une accumulation à long terme dans l'organisme, provoquant une cirrhose et un cancer du foie.
Par conséquent, il est préférable de jeter les petits pains collants d'été, plutôt que de les "chauffer", d'arracher les poils verts avant de les manger, car la plupart des aflatoxines sont invisibles à l'œil nu.
2, Alcool.
Une consommation excessive d'alcool augmente la charge sur le foie et provoque une hépatite et une cirrhose. L'alcool est métabolisé par le foie et l'acétaldéhyde produit au cours du métabolisme de l'alcool est un "tueur" de cellules hépatiques, et une consommation excessive d'alcool peut provoquer des maladies du foie.
En outre, l'alcool est interdit aux personnes souffrant d'une maladie du foie ; de nombreux cas d'hépatite alcoolique et de cirrhose alcoolique sont causés par l'alcool, qui est également un agent cancérigène de classe 1.

Arrêtez de boire de l'alcool lorsque vous prenez de l'âge, vous pouvez boire du thé qui est un excellent moyen de garder votre foie en bonne santé.
Le thé de réglisse Yang, bon pour le foie, contient des graines de casse, de la chicorée, des baies de goji, des racines de leucaena, du pissenlit, selon les proportions scientifiques, pour faire un thé.
3. aliments riches en protéines
La consommation d'aliments riches en protéines est censée être bénéfique pour la réparation du foie, mais après l'apparition d'une maladie du foie, une consommation excessive d'aliments riches en protéines est susceptible de provoquer un coma hépatique, ce qui est plus dangereux.

Comme l'ammoniac est l'un des métabolites des protéines dans l'organisme et que le foie est responsable de l'élimination de l'ammoniac, en cas de maladie du foie, l'ammoniac ne peut pas être éliminé normalement et l'ammoniac pénètre dans les vaisseaux sanguins du cerveau avec le sang, ce qui peut induire une encéphalopathie hépatique et conduire au coma.
Conclusion : après 50 ans, toutes les fonctions du foie commencent à décliner, si l'on ne prend pas bien soin du foie, la cirrhose finira tôt ou tard par frapper à la porte, c'est pourquoi il faut généralement veiller à contrôler son propre régime alimentaire, à développer de bonnes habitudes de vie, à constater que le corps est anormal, à consulter en temps utile.
Ces questions et réponses proviennent des utilisateurs du site, elles ne représentent pas la position du site, s'il y a une infraction, veuillez contacter l'administrateur pour la supprimer.